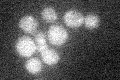
YPL004C
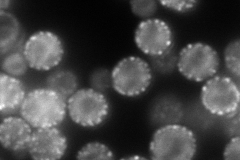
YPL004C
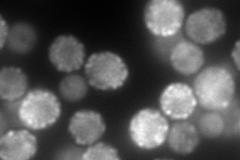
YPL004C

View description
Primary component of eisosomes, which are large immobile patch structures at the cell cortex associated with endocytosis, along with Pil1p and Sur7p; null mutants show activation of Pkc1p/Ypk1p stress resistance pathways
Localization:
Intensity:
Fold change:
Significance:
-
C’ GFP library in SD
below threshold15.64 -
N' NOP1pr-GFP in SD
cell periphery,punctate294.559 -
N' TEF2pr-mCherry in SD
cell periphery,punctate334.352 -
N' NATIVEpr-GFP in SD

cell periphery,punctate24.9861 -
N' TEF2pr-VC and Cyto-VN in SD

#N/A0 -
C’ GFP library in SD+DTT

cytosol17.21.09No -
C’ GFP library in SD+H2O2

cytosol17.151.09No -
C’ GFP library in Starvation Media

cytosol15.380.98No -
C’ GFP library on the background of Pup2-DaMP

below threshold -
C’ GFP library on the background of CCT mutant

below threshold16.48791.05408No
